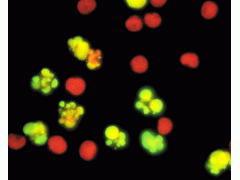

| 提交询价信息 |
| 发布紧急求购 |

价格:电议
所在地:上海
型号:
更新时间:2019-10-31
浏览次数:1345
公司地址:上海市闵行莘庄工业区春东路508号A1-2F
![]()
陈军 (先生) 徐经理
上海信裕生物科技有限公司是一家生物高新技术企业,主要从事免疫学、分子生物学和常规生化试剂的研发、销售。并代理销售Amresco,qiagen,GenWay,Sciencell,Millipore,eBioscience,Sigma、R&D、GBD、ATCC、HYCLONE等二十多家国内外知名品牌,致力于为广大高校、科研院所和企业单位提供的科研试剂和完善的技术服务,满足生物化学、分子生物学 、细胞生物学、免疫学 ELISA试剂盒等生物科技实验需求。
上海信裕先后与天津中医学院、复旦大学、上海交通大学医学院、上海交通大学、华东师范大学、第二军医大学、南京大学,暨南大学,南京工业大学,曙光医院、华山医院、瑞金医院、上海有机研究所、中科院上海分院等多家单位建立了良好的合作关系。本公司可为您提供科研ELISA试剂盒,种属标本齐全,有专门针对人血清、血浆、全血、分泌物、尿液、细胞培养上清液、组织匀浆、组织液等标本的试剂盒;另有针对各种动物(鼠、兔、牛、马、鸡、猪、狗、山羊、猴、鱼)的科研试剂。
公司秉承“专注品质、信守承诺、积极沟通、创新服务”的企业文化积极参与生物领域的技术创新和技术服务,力求为我国科研事业,专业的服务!
其主营产品:ELISA试剂盒/人ELISA试剂盒/大鼠ELISA试剂盒/小鼠ELISA试剂盒/金标试剂盒/免疫组化试剂盒/标准品/科研抗体/生化试剂,生物培养基/细胞株/实验室耗材/动物血清等科研产品
小鼠神经细胞瘤,NG108-15
【规 格】1株/1ML
【储存条件】低温保存
【产品商标】ATCC
【供应限制】仅供科研使用
细胞培养的准备工作一定要做充分,准备至少两套高温高压消毒后的物品,做新的操作时先检点所有的东西是否准备齐全,比如配液时的滤器,分装所用的容器是不是足够等等。所有实验物品,包括自己配的液体和购买的产品,都要标记清楚(比如名称,PH值、时间、还有自己的名字,如果是共用一个冰箱的话这一点很重要)。冻存的物品尽量避免反复冻融,如果无法避免,也要尽早分装,一次用完。小鼠神经细胞瘤,NG108-15细胞计数在开始培养时很有必要,但计数次数多了经验估计法也是很好的办法,必竟每次计数也不是那么,而细胞培养对计数也不是那么要求严格。 一瓶细胞培养用液体尽量不要反复使用,这将增大污染机率。可用的办法即是将其分装成适当规格,一次用1瓶。细胞培养板或瓶若要摞在一起的话,注意在箱内不要超过3层,否则,中间的会受热不均,严重影响细胞质量,可造成细胞生长不均匀,可能造成中间稀少,四周密集。
本公司是一家生物高新技术企业,满足生物化学、分子生物学 、细胞生物学、免疫学 ELISA试剂盒等生物科技实验需求,其主营产品:ELISA试剂盒/人ELISA试剂盒/大鼠ELISA试剂盒/小鼠ELISA试剂盒/金标试剂盒/免疫组化试剂盒/标准品/科研抗体/生化试剂,生物培养基/细胞株/实验室耗材/动物血清等科研产品!
产品展示台:
ELISA试剂盒 科研抗体
人穿孔素/成孔蛋白(PF/PFP)ELISA试剂盒 卵黄蛋白原抗体
人神经调节蛋白1(NRG-1)ELISA试剂盒 X-连锁凋亡蛋白/性连锁凋亡抑制蛋白抗体人干扰素调节因子(IRF)ELISA试剂盒 包含氧化还原酶的WW域抗体
人白三烯D4(LTD4)ELISA试剂盒 生精细胞凋亡相关基因3抗体
人结缔组织活化肽Ⅲ(CTAPⅢ)ELISA试剂盒 辣根过氧化物酶标记β-肌动蛋白(抗体)ATCC细胞 标准品
小鼠肺腺癌细胞系 马钱子碱
小鼠乳腺癌细胞 芦竹碱
大鼠肉瘤细胞 补骨脂素
大鼠卵巢癌细胞 迷迭香酸
小鼠浆细胞瘤 盐酸药根碱
小鼠网织细胞肉瘤 木香烃内酯
生化试剂 生物培养基
L-丙氨酸 肠球菌琼脂
L-硫氢化氨基丙酸 Endo 培养基
DL-半膀胱氨基酸 肠道菌增菌肉汤(EE肉汤)
L-硝基精氨酸 标准II号营养琼脂
N-叔丁氧羰基-D-丙氨酸 苯丙氨酸脱氨酶培养基
以上为本公司其他类产品部分展示,如有其他产品需求可来电详询,或登录 查询:信裕生物:http://shxysw.18.geilan.com/
小鼠神经细胞瘤,NG108-15技术相关问答:
1. 如何选用特殊细胞系培养基?培养某一类型细胞没有固定的培养条件。在MEM中培养的细胞,很可能在DMEM或M199中同样很容易生长。总之,MEM做粘附细胞培养、RPMI-1640做悬浮细胞培养是一个好的开始。2. 何时须更换培养基?视细胞生长密度而定, 或遵照细胞株基本数据上之更换时间,按时更换培养基即可。 3. 可否使用与原先培养条件不同之培养基?不能。每一细胞株均有其特定使用且已适应之细胞培养基, 若骤然使用和原先提供之培养条件不同之培养基, 细胞大都无法立即适应, 造成细胞无法存活。4.可否使用与原先培养条件不同之血清种类?不能。血清是细胞培养上一个为重要的营养来源,所以血清的种类和品质对于细胞的生长会产生大的影响。来自不同物种的血清, 在一些物质或分子的量或内容物上都有所不同,血清使用错误常会造成细胞无法存活。
相关产品:
TC-axbz-259 绿色荧光蛋白标记小鼠子宫颈癌细胞 U14-GFP
TC-axbz-260 小鼠浆细胞瘤 MPC-11
TC-axbz-261 转PYTL基因小鼠睾丸支持细胞 15P-1
TC-axbz-262 BALB/C小鼠肝上皮细胞 BNL1ME A.7R.1
TC-axbz-264 小鼠网织细胞肉瘤 M5076
TC-axbz-265 小鼠正常肝细胞 NCTC1469
编号 中文 英文名称
TC-axbz-266 正常小鼠睾丸Leydig细胞 TM3
TC-axbz-268 615小鼠乳腺癌瘤株 Ca759
TC-axbz-271 615小鼠T细胞性白血病瘤株 L7712
TC-axbz-273 615小鼠肺癌瘤株 HP615
TC-axbz-274 615小鼠滑膜肉瘤瘤株 ZM755
TC-axbz-275 615小鼠乳头状肺腺癌瘤株 P615
TC-axbz-276 KM小鼠子宫颈癌瘤株 U27
TC-axbz-277 KM小鼠网织细胞肉瘤瘤株 LⅡ
TC-axbz-278 KM小鼠脑神经胶质母细胞瘤瘤株 G422
TC-axbz-279 615小鼠网织细胞性白血病瘤株 L615
TC-axbz-280 Walker氏癌肉瘤256瘤株 W256
TC-axbz-281 C57小鼠黑色素瘤瘤株 ME
TC-axbz-282 KM小鼠未分化神经胶质瘤瘤株 B22
TC-axbz-283 小鼠Lewis肺癌瘤株 LLT
TC-axbz-284 615小鼠前胃癌瘤株 Fc
TC-axbz-285 小鼠乳腺癌细胞株 EMT-6
TC-axbz-286 小鼠肾癌细胞株 RuCa
TC-axbz-287 大鼠肉瘤细胞 WK256
TC-axbz-289 大鼠胰腺癌细胞株 DSL-6A/C1
TC-axbz-291 大鼠卵巢癌细胞株 NUTU-19
TC-axbz-295 小鼠胰腺腺泡细胞癌细胞 MPC-83
编号 中文 英文名称
TC-axbz-297 小鼠β胰岛素瘤细胞 RIN-m5F
TC-axbz-298 小鼠自发高乳腺癌细胞 TA2
TC-axbz-302 HPVl6 E6、E7和ras基因共转化的C57BL/C(H-2b)小鼠肺上皮细胞 TC-1
内皮细胞细胞株
TC-hxbz-393 人血管内皮细胞 VE
TC-hxbz-395 人脐静脉血管内皮细胞 HUVEC
编号 中文 英文名称
TC-hxbz-400 人肠系膜下腔动脉血管内皮细胞 Ealy926
人泌尿系统细胞株
TC-hxbz-205 人肾癌细胞 Ketr-3
TC-hxbz-207 人肾透明细胞腺癌细胞 786-O
TC-hxbz-208 人肾小球髓母细胞 HBZY-1
TC-hxbz-209 人肾小球系膜细胞 HMC
TC-hxbz-210 人肾上腺皮质腺癌细胞 NCI-295R
TC-hxbz-211 HEK293,人胚肾上皮细胞 293A
TC-hxbz-213 SV40永生化的人胚肾上皮细胞 293T
TC-hxbz-214 SV40T转化的人胚肾细胞(亚系) 293T/17
TC-hxbz-215 人类胚胎肾脏表皮细胞 H293T
TC-hxbz-216 人胚肾细胞(亚系克隆) FIP293
TC-hxbz-217 稳定表达EBNA1的人胚肾细胞 293E
TC-hxbz-218 表达SV40T和EBNA1的人胚肾细胞 293ET
TC-hxbz-220 Ad5DNA转化的胚肾 HEK-293
TC-hxbz-221 人原胚肾转化细胞系 293 Ad5+
TC-hxbz-222 表达SV40T抗原人胚肾上皮细胞 293FT
TC-hxbz-223 人人胚肾细胞 AAV-293
TC-hxbz-224 人胚肾上皮包装细胞 GP2-293
TC-hxbz-226 人肾上腺腺瘤细胞 NCI-H205
TC-hxbz-230 人肾小管近段上皮细胞 HK-2
TC-hxbz-231 人肾上腺神经母细胞瘤细胞(脑转移) KP-N-NS
TC-hxbz-234 人肾癌细胞系(769-P) 769-P
TC-hxbz-235 人肾透明细胞癌皮肤转移细胞 Caki-1
TC-hxbz-237 人肾癌细胞系 A498
 免责声明:以上所展示的[ 小鼠神经细胞瘤,NG108-15]信息由会员[上海信裕生物科技有限公司]自行提供,内容的真实性、准确性和合法性由发布会员负责。
免责声明:以上所展示的[ 小鼠神经细胞瘤,NG108-15]信息由会员[上海信裕生物科技有限公司]自行提供,内容的真实性、准确性和合法性由发布会员负责。